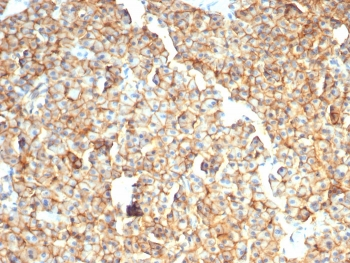
EpCAM Antibody

You have no items in your shopping cart.
Search results for: 'antibody'
- Recombinant Aurora B Antibody / AURKB [orb640032]
IHC-P
Human
Mouse
Recombinant
Unconjugated
20 μg, 100 μg - Recombinant CD44 Antibody / HCAM [orb640057]
FACS, IF, IHC-P, WB
Human
Mouse
Recombinant
Unconjugated
100 μg, 20 μg - Featured
Kir2.1 Antibody (FITC) [orb148332]Featured
AM, ICC, IF, IHC, WB
Human, Monkey, Mouse, Rat
Mouse
Recombinant
FITC
100 μg - Featured
Kir2.1 Antibody (HRP) [orb148333]Featured
AM, ICC, IF, IHC, WB
Human, Monkey, Mouse, Rat
Mouse
Recombinant
HRP
100 μg - Featured
Kir2.1 Antibody (RPE) [orb148336]Featured
AM, ICC, IF, IHC, WB
Human, Monkey, Mouse, Rat
Mouse
Recombinant
RPE
100 μg